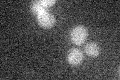
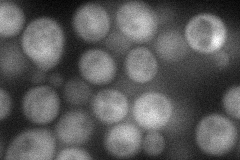
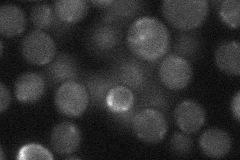

View description
Protein that acts together with Uba3p to activate Rub1p before its conjugation to proteins (neddylation), which may play a role in protein degradation
Localization:
Intensity:
Fold change:
Significance:
-
C’ GFP library in SD
below threshold15.35 -
N' NOP1pr-GFP in SD
cytosol56.4264 -
N' TEF2pr-mCherry in SD

ER,vacuole0 -
N' NATIVEpr-GFP in SD
cytosol21.4421 -
N' TEF2pr-VC and Cyto-VN in SD

#N/A0 -
C’ GFP library in SD+DTT

cytosol18.631.21No -
C’ GFP library in SD+H2O2

cytosol17.061.11No -
C’ GFP library in Starvation Media

cytosol18.111.17No -
C’ GFP library on the background of Pup2-DaMP

below threshold -
C’ GFP library on the background of CCT mutant

below threshold14.79510.962953No
